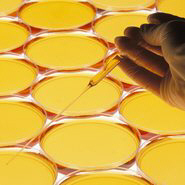

Langileen estatistika Euskal AEko sektore publikoan
2026/01/16Estatistikak

Ikerketa zientifiko eta garapen teknologikoko jarduerei buruzko estatistika-I+G
2026/01/16Estatistikak

Sektore publikoaren aurrekontuen estatistikak
2025/12/19Estatistikak
Gizarte-Iarrialdietarako laguntzen estatistika
2025/12/18Estatistikak